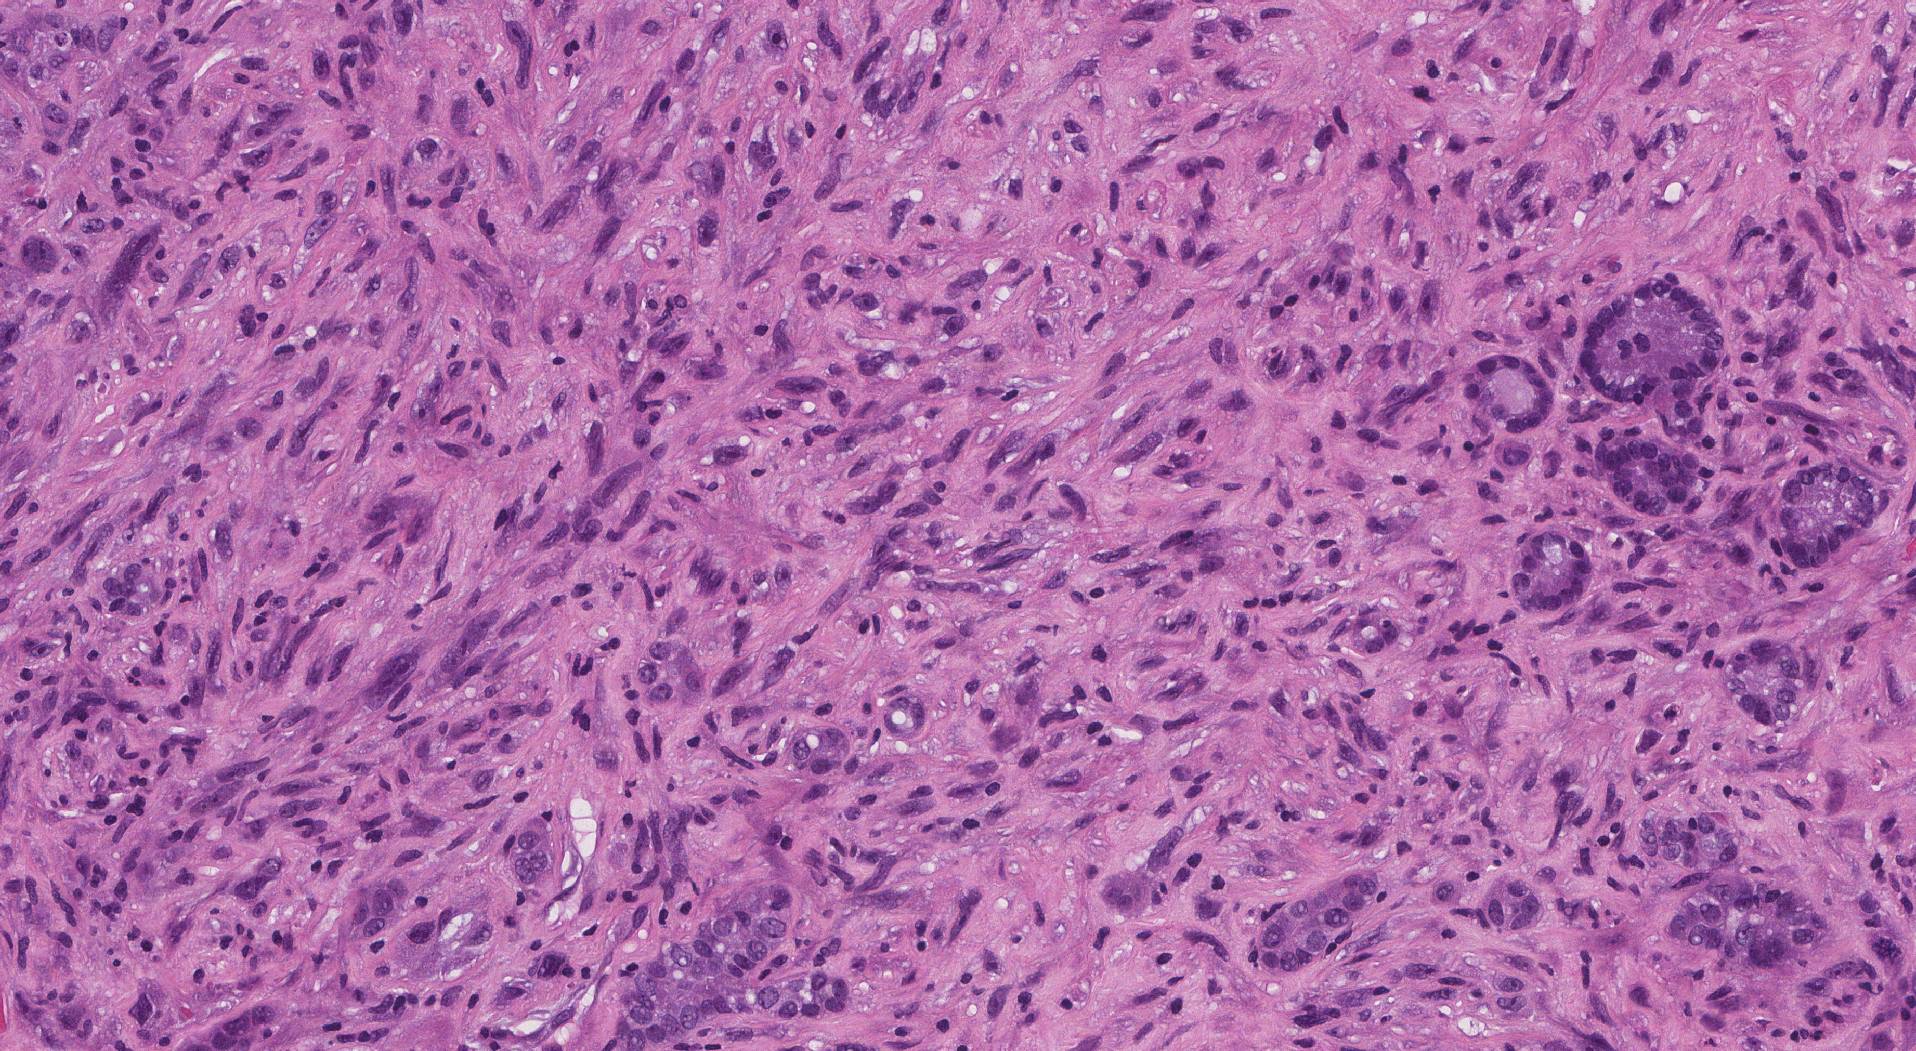
Carcinoma anaplastico della tiroide: gestione e nuove terapie (aggiornamento 2025)

Introduzione
Il carcinoma anaplastico della tiroide (ATC) rappresenta meno dell’1–2 % di tutti i tumori tiroidei, ma è responsabile di oltre il 50 % dei decessi correlati a neoplasie tiroidee. È una forma altamente aggressiva, caratterizzata da rapida crescita locale, invasione delle strutture cervicali e frequente metastatizzazione a distanza. La sopravvivenza mediana rimane inferiore a 6 mesi, rendendolo una delle neoplasie solide più letali.
Diagnosi e stadiazione
Alla diagnosi, la maggior parte dei pazienti presenta malattia localmente avanzata o metastatica. La biopsia con analisi molecolare è oggi imprescindibile: l’identificazione di mutazioni target (BRAF V600E, RET, NTRK, ALK) consente l’accesso a terapie mirate efficaci. La TC cervico-toracica, la PET/TC e la valutazione della via aerea sono parte integrante della stadiazione e della pianificazione terapeutica.
Approccio terapeutico multidisciplinare
Le linee guida più recenti (ATA 2021; ESMO e NCCN 2024) raccomandano un team multidisciplinare composto da chirurgo endocrino, oncologo, radioterapista, anestesista e palliativista. L’obiettivo principale è il controllo locale e il mantenimento della pervietà delle vie aeree.
Trattamento chirurgico
La resezione chirurgica radicale (R0/R1) è indicata solo nei casi potenzialmente operabili, seguita da radioterapia post-operatoria con eventuale chemioterapia concomitante. Nei casi inoperabili alla diagnosi, la chirurgia palliativa (tracheotomia, debulking) viene riservata ai pazienti con rischio imminente di ostruzione respiratoria.
Radioterapia e chemioterapia
La radioterapia a intensità modulata (IMRT) rappresenta lo standard nel setting postoperatorio o per il controllo locale della malattia non resecabile. La chemioterapia tradizionale ha efficacia limitata. I regimi più utilizzati includono paclitaxel ± carboplatino o doxorubicina, ma le risposte sono spesso transitorie. Tuttavia, la chemioterapia può essere utile in combinazione con la radioterapia o come ponte verso terapie mirate.
Terapie mirate e immunoterapia
Negli ultimi anni, l’introduzione di terapie a bersaglio molecolare ha profondamente cambiato la gestione dell’ATC:
- Mutazione BRAF V600E → dabrafenib + trametinib (risposte >60%).
- Fusione RET → selpercatinib o pralsetinib.
- Fusione NTRK → larotrectinib o entrectinib.
- Espressione PD-L1 elevata → pembrolizumab o nivolumab, talora in combinazione con lenvatinib.
Gestione palliativa e supportiva
Nei casi refrattari o in rapido deterioramento clinico, l’obiettivo diventa il controllo sintomatologico: radioterapia palliativa, gestione del dolore, supporto respiratorio e nutrizionale. Le cure palliative devono essere integrate precocemente.
Prospettive future
Le nuove linee guida sottolineano l’importanza di:
- Test genetico rapido su biopsia o DNA circolante per terapia personalizzata;
- Approccio neoadiuvante con terapie target per rendere operabili tumori inizialmente inoperabili;
- Combinazioni target + immunoterapia per potenziare la risposta.
Conclusioni
Il carcinoma anaplastico della tiroide, un tempo intrattabile, sta vivendo un’evoluzione terapeutica significativa grazie alla medicina di precisione. L’identificazione precoce delle mutazioni target e l’uso combinato di terapie mirate e immunoterapia hanno migliorato la prognosi in sottogruppi selezionati, spostando il paradigma da un approccio puramente palliativo a uno sempre più personalizzato.
Bibliografia essenziale
American Thyroid Association Guidelines for ATC, Thyroid 2021
NCCN Guidelines v.2024 – Thyroid Carcinoma
ESMO Clinical Practice Guidelines 2024
Subbiah V. et al., Lancet Oncol 2023; Nat Rev Endocrinol 2024
Brose M.S. et al., J Clin Oncol 2024